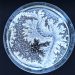
Sulle orme di uno scienziato (Daniela Fadda)

Arte, poesia, romanzi e racconti, riflessioni, fotografia, creatività, innovazione, musica: questi e tanti altri gli ingredienti di Pazza Idea, il festival ideato e organizzato dall’associazione Luna Scarlatta che porta ogni anno a Cagliari un ricco programma di incontri culturali con ospiti da tutto il mondo. La dodicesima edizione dal suggestivo titolo “Abitare trasformazioni” è stata presentata venerdì mattina negli spazi del Ghetto, nel cuore del quartiere storico di Castello che da sempre ospita il festival, dalla direttrice artistica Mattea Lissia: “Un’edizione, questa, che si dichiara subito ‘colpevole’ dei reati di curiosità e apertura verso il mondo, centrata sulla trasformazione e i mutamenti della società, che possono intimorire perché percepiti come manifestazione di quella complessità che è là fuori, ma allo stesso tempo sono forieri di evoluzione e umanità che è poi sempre il nostro interesse principale. In questo nostro percorso ormai ultradecennale, la nostra curiosità e la nostra passione – per quello che ci accade intorno è scoperta, esplicita, fin dal titolo scelto. Le trasformazioni non si osservano passivamente, ma si abitano: quelle fuori e quelle dentro di noi. Sentimenti, emozioni, legami e nuovi alfabeti della relazioni, i cambiamenti del post-pandemia, le forme del lavoro e le scelte sui linguaggi, la comunicazione a ogni livello, e al centro l’umanità e le sue contraddizioni”.
Pazza Idea sarà in città tra giovedì 23 e domenica 26 novembre: un lungo fine settimana dedicato alla letteratura, il digitale, la poesia, i femminismi, l’Intelligenza Artificiale, la comunicazione e come sempre ai grandi temi della contemporaneità, spaziando dal privato al pubblico con storie e testimonianze e confronti fra pubblico e autrici e autori. Il festival è realizzato con il contributo della Regione Autonoma della Sardegna, del Comune di Cagliari e della Fondazione di Sardegna e in collaborazione con la Fondazione Cesare Pavese, il MUACC- Museo universitario delle arti e delle culture contemporanee e CTM Spa; il progetto ha il patrocinio dell’Università degli Studi di Cagliari.
Gli ospiti
Protagonisti e protagoniste della letteratura italiana e internazionale, del giornalismo, della poesia, della fotografia, dell’attivismo nel campo del femminismo e dei diritti umani, della filosofia, dei linguaggi e della comunicazione animeranno le quattro giornate del festival con momenti di rilfessione e approfondimento. Tra i nomi più attesi Fabio Lovino, fotografo che ha ritratto, tra i tanti, Al Pacino, Martin Scorsese, Terry Gilliam, Isabelle Huppert (giovedì 23 alle 19.40), Matteo B. Bianchi, autore del bellissimo “La vita di chi resta” pubblicato pochi mesi fa da Mondadori attorno al tema del suicidio (sarà a Cagliari venerdì 24 novembre alle 18); Vera Gheno, Giulia Siviero e Giusi Marchetta sul tema “Per fortuna ci sono le ragazze” (venerdì alle 19); Veronica Raimo, scrittrice appena arrivata in libreria per Einaudi con i racconti “La vita è breve, eccetera” (venerdì alle 20); Patrizia Valduga, poetessa che porta per la prima volta in Italia il recital “Uno strato di buio, uno di luce” accompagnata dal musicista di bandoneon Daniele di Bonaventura (venerdì alle 21); Roberto Cotroneo, autore del recente “La cerimonia dell’addio” per Mondadori (sabato alle 18); lo storico Enrico Deaglio che presenta l’ultimo volume della serie “C’era una volta in Italia” dedicato agli anni Sessanta (sabato alle 20); Leo Ortolani, disegnatore, che dopo il grande successo con il personaggio di Ratman arriva in libreria per Feltrinelli Comics con “I tarocchi” (domenica alle 11); Melania Mazzucco presenta “Self Portrait, il museo del mondo delle donne” (domenica alle 16); Milo De Angelis, poeta che ha firmato il recente “De rerum natura di Lucrezio” (domenica alle 19).
La musica e l’arte
Non solo libri e letture: il festival da sempre dedica un grande spazio alla musica nel suo rapporto con comunicazione, linguaggio e arte. Il compositore Luigi Frassetto accompagnerà Andrea Bosca nel reading redicato a Italo Calvino (giovedì alle 18.45), la cantautrice, esperta d’arte e scrittrice Maria Antonietta presenterà la performance “Non ho intenzione di deluderti, ma questa e la mia faccia” in collaborazione con il Museo Universitario delle arti e delle culture contemporanee (sabato alle 21), Emanuele Contis creerà la colonna sonora per la mattina di poesie in programma domenica alle 12, il musicista napoletano Giovanni Truppi incontrerà il pubblico domenica alle 20. Chiuderà il festival il dj set di JaneD e Miss Marylight. Le sale del Ghetto ospiteranno la mostra “Tali e quadri” dell’illustratore Fabio Magnasciutti, una visione tagliente e ironica sull’attualità e il mondo che viviamo.
I workhop
Tra le attività proposte da Luna Scarlatta ci sono i workshop gratuiti su prenotazione, rivolti a tutti e tutte e in particolare al mondo universitario anche in collaborazione con il Corso di Laurea di Scienze della Comunicazione; nell’edizione 2023 si parlerà di ecopacifismo con un focus su Alexander Langer, social reading, scrittura musicale, uso sostenibile dei social media, sperimentazioni con l’AI generativa con Vera Gheno, Lavinia Bianchi, Pierluigi Vaccaneo, Ilaria Gaspari, Mafe De Baggis, Fabio Magnasciutti, Ilaria Porceddu.
Il programma completo si trova qui, tutti gli appuntamenti hanno ingresso libero e gratuito.